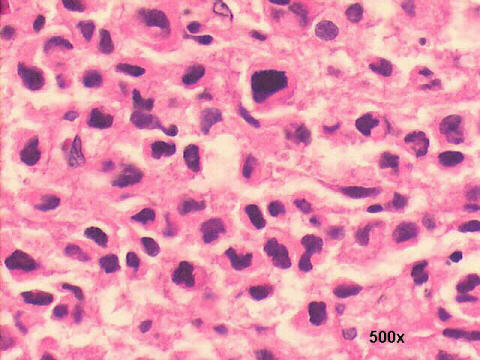
Anaplastic cells H&E 500x

Hospital de Clínicas de Porto Alegre,
Cytopathology Laboratory

FNA cytology
revealed several flame cells and plasmablasts suggestive of myelomatous
lesion. Bone marrow biopsy of the rib lesion ( see above pictures) showed
focal replacement by anaplastic cells considered anaplastic carcinoma.


Iliac crest marrow
aspiration showed large numbers of plasma cells and plasmablasts, several
with the same flame cell morphology seen in the rib lesion FNA. (see above)
Serum immune-electrophoresis
revealed a monoclonal IgA type of peak. Immune-histochemistry of the bone
biopsy was negative for epithelial and leukocyte markers ("bald cells").
The thyroid nodule FNA revealed a plasmacytoma type of lesion. The patient
had a bad response to chemotherapy, developed renal insufficiency and died
of the disease three months later.
Porto Alegre,
RS Brazil